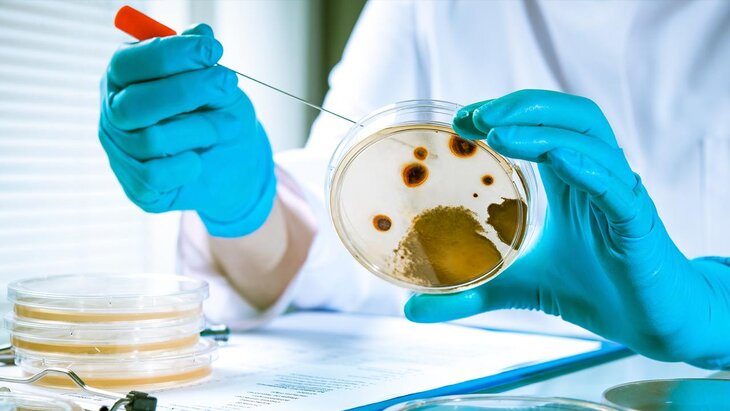

Роспотребнадзор о холере: ситуация в РФ стабильная, перебоев в системе водоснабжения нет
Фото: depositphotos/alexraths
Санитарно-эпидемиологическая ситуация в Херсонской области остается стабильной, рассказали РИА Новости представители пресс-службы Роспотребнадзора.
В ведомстве назвали ситуацию в регионе контролируемой и подчеркнули, что в распределительной сети и системе водоснабжения не было зафиксировано перебоев. Кроме того, специлисты не выявили на территории области случаев заболевания холерой.
В настоящее время ситуация в Херсонской области остается на строгом контроле Роспотребнадзора, подчеркнули представители ведомства.
Ранее подполье Херсона заявило о госпитализации около 100 заболевших холерой и гибели не менее 12 человек от этого заболевания.
Роспотребнадзор направил экстренный запрос в европейское бюро Всемирной организации здравоохранения (ВОЗ) для подтверждения данных о вспышке холеры на территории региона. После этого было принято решение об усилении контроля за санитарно-эпидемиологической обстановкой на приграничных территориях РФ.
Спустя некоторое время представители Роспотребнадзора заявили, что в течение 2024 года в новых российских регионах не было обнаружено ни одного случая заражения. В ведомстве также отметили, что в настоящее время уделяют особое внимание мониторингу ситуации на юге страны, в том числе в новых субъектах.